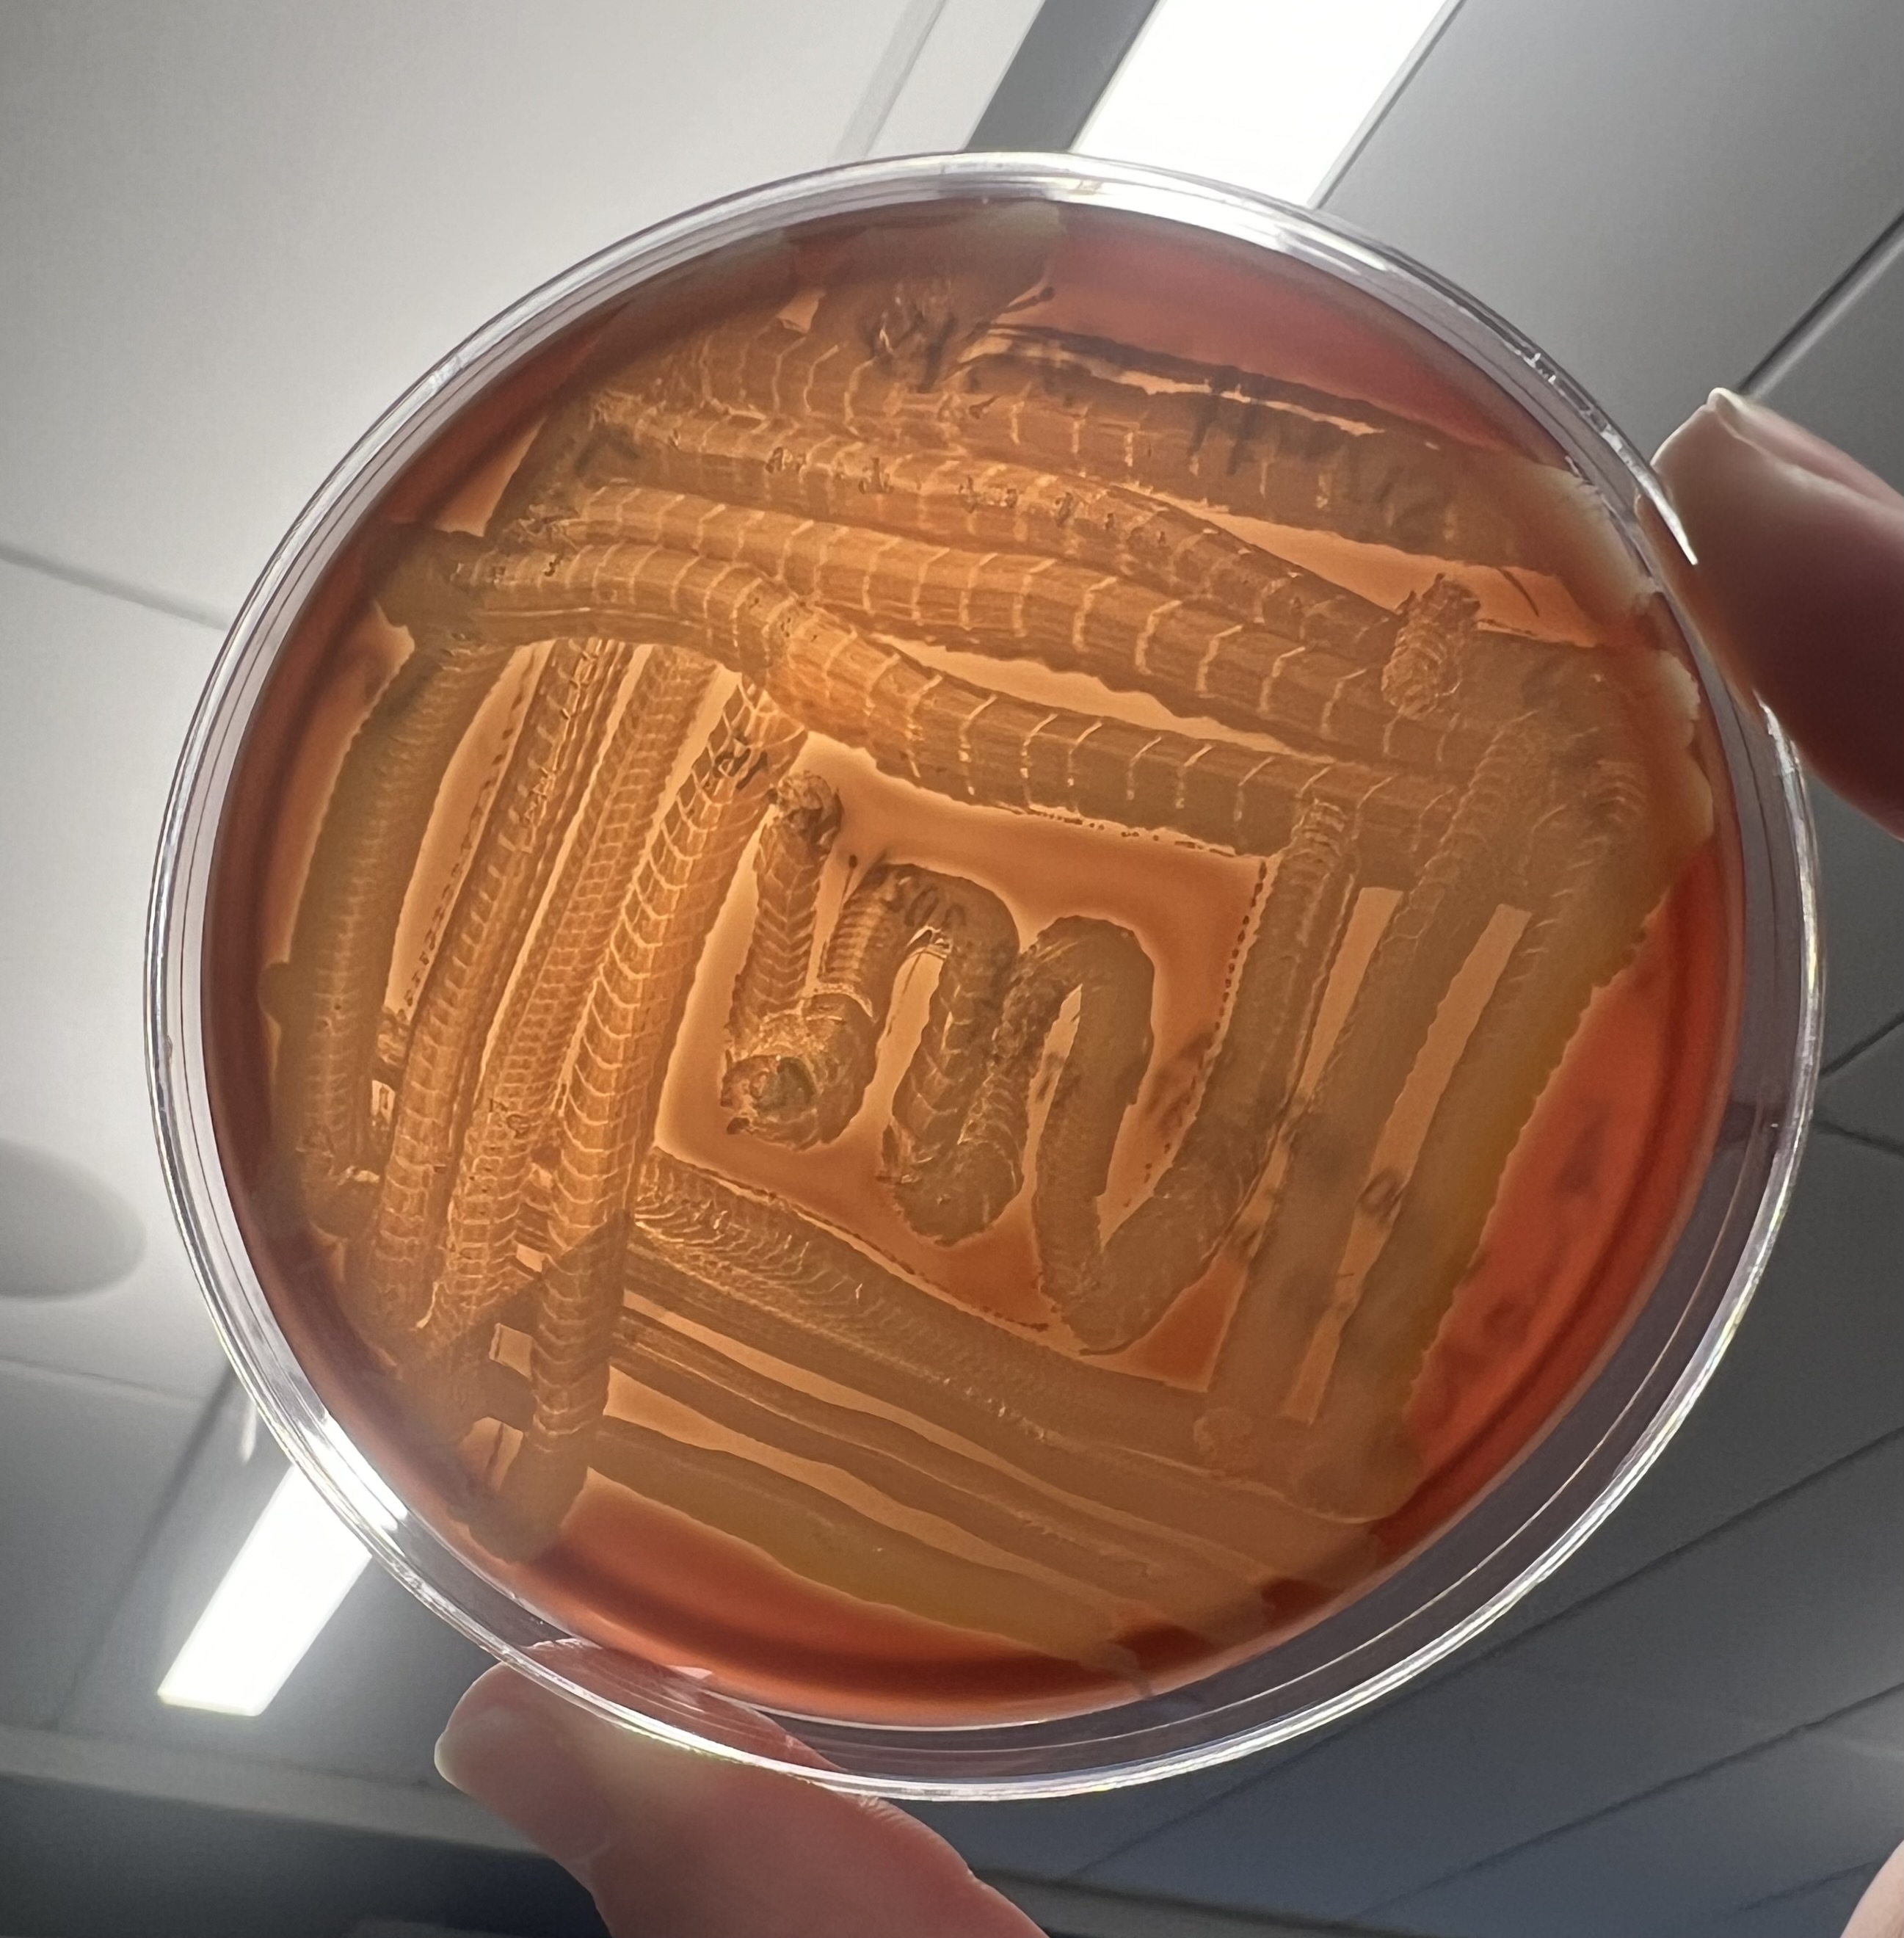

· hemolysis refers to the lysis, or breakdown, of red blood cells. Hemolysis occurs … · sometimes, medical conditions can cause abnormal hemolysis. Increased hemolysis occurs … · hemolysis hemolysis is the breakdown of red blood cells. After that, they naturally break down and are most often removed from … This can result in symptoms ranging from fatigue to dizziness to loss of consciousness—depending on the … Hemolysis can occur within the blood vessels (intravascular hemolysis) or outside of them (extravascular hemolysis), primarily in the spleen and liver. · hemolysis, breakdown or destruction of red blood cells so that the contained oxygen-carrying pigment hemoglobin is freed into the surrounding medium. Anemia results when bone marrow production can no longer compensate for the … However, some conditions, medications, and toxins may cause rbcs to break … Red blood cells normally live for 110 to 120 days. The condition can be acute or … · hemolysis is the medical term used to describe the destruction of red blood cells. Hemolysis may occur if the centrifuge rotates too quickly (generally greater than 500 rpm)—essentially this is hemolysis occurring outside of the body. Your body is constantly destroying old or damaged red blood cells and replacing them with … · hemolysis is a natural process where the body destroys older rbcs that no longer work efficiently. Excessive hemolysis can cause a low amount of rbcs and lead to hemolytic anemia. Physiologically, mature red blood cells, or erythrocytes, have a relatively long lifespan during which they travel … Hemolysis is defined as premature destruction and hence a shortened rbc life span (< 120 days). · hemolysis refers to the natural destruction of old or damaged red blood cells (rbcs).
Hemolysis Index 0 24: What Does It Really Mean?
· hemolysis refers to the lysis, or breakdown, of red blood cells. Hemolysis occurs … · sometimes, medical conditions can cause abnormal hemolysis. Increased hemolysis...